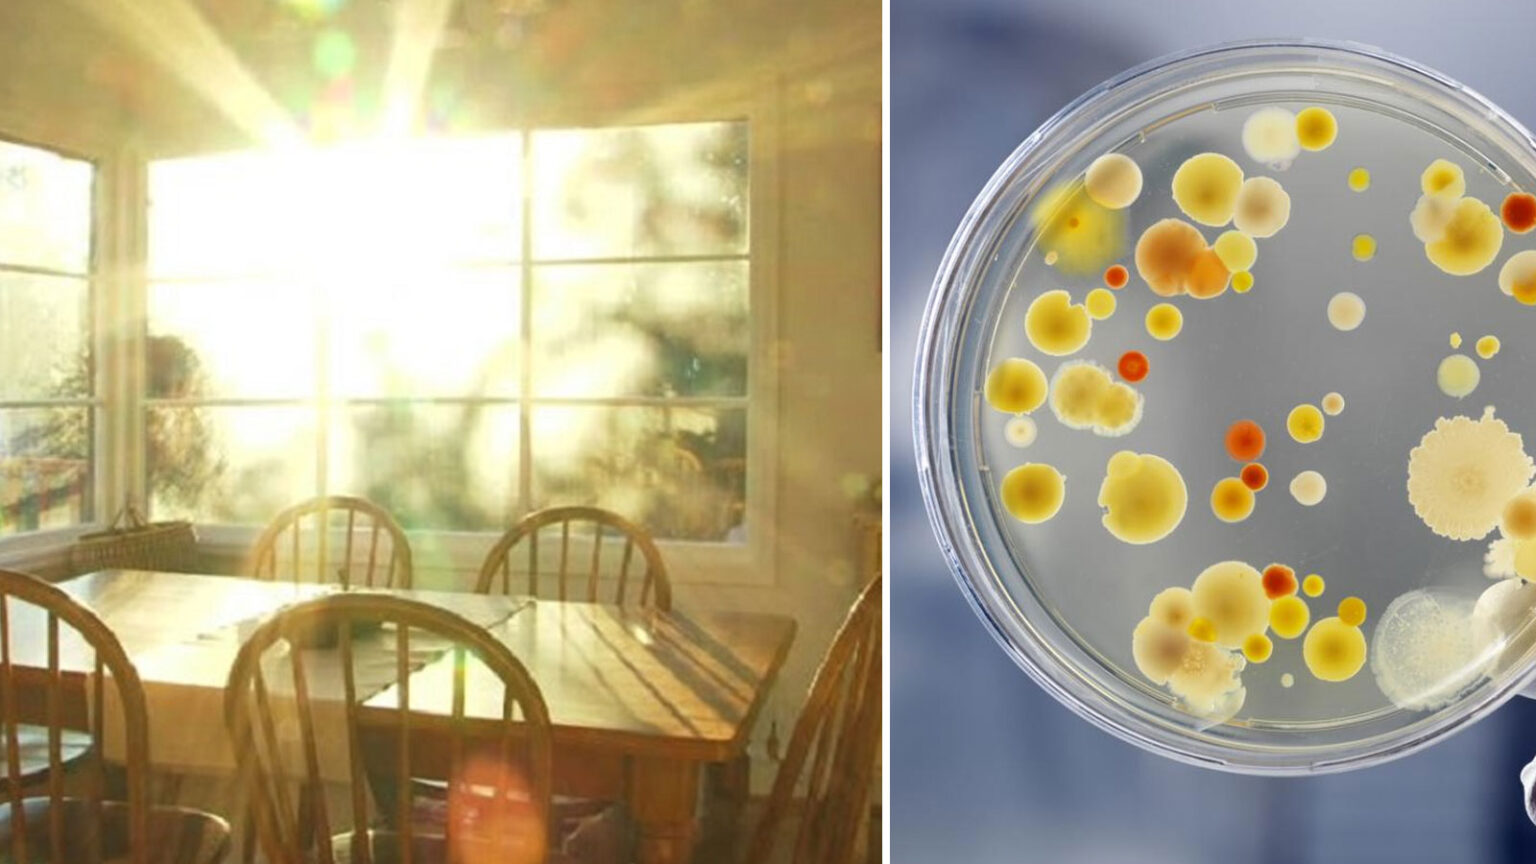
Ανοίξτε τις κουρτίνες! Ή ίσως να φτιάξετε περισσότερα παράθυρα! Μελέτη διαπιστώνει ότι το φως του ήλιου είναι το καλύτερο απολυμαντικό!

Ανοίξτε τις κουρτίνες! Ή ίσως να φτιάξετε περισσότερα παράθυρα! Μελέτη διαπιστώνει ότι το φως του ήλιου είναι το καλύτερο απολυμαντικό! Τα Οφέλη της Ηλιοθεραπείας Υπερτερούν κατά πολύ των Κινδύνων, Σύμφωνα με τον Παγκόσμιο Οργανισμό Υγείας

Τα δωμάτια που λούζονται στο φως του ήλιου έχουν περίπου τα μισά βιώσιμα βακτήρια από τα σκοτεινά δωμάτια και σχεδόν κανένα βακτήριο που προκαλεί αναπνευστικές ασθένειες, διαπίστωσε μια μελέτη που δημοσιεύτηκε στο Microbiome.
Ερευνητές στο Πανεπιστήμιο του Όρεγκον έφτιαξαν πολλά δωμάτια σε μέγεθος κουκλόσπιτου, μερικά με κανονικό γυαλί που μπλοκάρει την υπεριώδη ακτινοβολία, μερικά με γυαλί που αφήνει τις ακτίνες UV να μπουν και μερικά σκοτεινά.
Γέμισαν το καθένα με σκόνη γεμάτη βακτήρια που συλλέχθηκε από πραγματικά σπίτια στο Πόρτλαντ και τα έβαλαν έξω, ενώ διατηρούσαν το εσωτερικό σε κανονική θερμοκρασία δωματίου.
Δείτε ακόμη Βλάπτουν τους Πνεύμονες όσο το Κάπνισμα: Προσοχή Στα Είδη Καθαρισμού Οικιακής Χρήσης
Μετά από 90 ημέρες, ανακάλυψαν ότι το 12% των βακτηρίων ήταν ακόμα ζωντανά και βιώσιμα (ικανά να αναπαραχθούν) στα σκοτεινά δωμάτια. Τα δωμάτια που εκτέθηκαν στο φως της ημέρας μέσω γυαλιού που μπλοκάρει την υπεριώδη ακτινοβολία είχαν μόνο 6,8% βιώσιμα βακτήρια σκόνης και τα δωμάτια που άφηναν το υπεριώδες φως να εισχωρήσει είχαν μόνο το 6,1% βιώσιμων βακτηρίων που επιβίωσαν.
Η σκόνη στο σκοτάδι περιείχε είδη βακτηρίων που συνδέονται στενά με αναπνευστικές ασθένειες, τα οποία σε μεγάλο βαθμό απουσίαζαν στα δωμάτια που εκτέθηκαν στο φως της ημέρας.
Τα βακτήρια που επιβίωσαν στα ηλιόλουστα δωμάτια ήταν ως επί το πλείστον τα ίδια που θα βρίσκονταν στον εξωτερικό αέρα, υποδηλώνοντας ότι το ηλιακό φως κάνει το μικροβίωμα της σκόνης εσωτερικών χώρων να μοιάζει περισσότερο με τις βακτηριακές κοινότητες που βρίσκονται σε εξωτερικούς χώρους.
«Μέχρι τώρα, ο φωτισμός ενός κτιρίου με φυσικό φως αφορούσε την οπτική άνεση ή την ευρεία υγεία», δήλωσε στο NPR ο συν-συγγραφέας της μελέτης και συν-διευθυντής του Κέντρου Βιολογίας και Δομημένου Περιβάλλοντος Kevin Van Den Wymelenberg. «Αλλά τώρα μπορούμε να πούμε ότι ο φυσικός φωτισμός επηρεάζει την ποιότητα του αέρα».
«Οι άνθρωποι περνούν τον περισσότερο χρόνο τους σε εσωτερικούς χώρους, όπου η έκθεση σε σωματίδια σκόνης που μεταφέρουν μια ποικιλία βακτηρίων, συμπεριλαμβανομένων παθογόνων που μπορούν να μας αρρωστήσουν, είναι αναπόφευκτη», δήλωσε ο επικεφαλής συγγραφέας της μελέτης Ashkaan Fahimipour σε δελτίο τύπου.
Σε μελλοντικές μελέτες, οι ερευνητές είπαν ότι θα ήθελαν να προσδιορίσουν ακριβώς πόσο φως είναι απαραίτητο για να σκοτωθούν τα μικρόβια, ώστε οι αρχιτέκτονες να αρχίσουν να σχεδιάζουν κτίρια έχοντας αυτό κατά νου.
Ο Fahimipour εφιστά στην προσοχή στα οικιακά καθαριστικά που ισχυρίζονται ότι σκοτώνουν το 99,99% των βακτηρίων, καθώς η πλήρης εξάλειψη των μικροβίων είναι αδύνατη και ανεπιθύμητη ακόμα κι αν ήταν δυνατή.
«Η απολύμανση δεν είναι η καλύτερη προσέγγιση», είπε στο NPR. «Και κάποια μικρόβια είναι πραγματικά καλά για εμάς, όπως αυτά στο γιαούρτι. Ίσως είναι καλύτερο να εμπλουτίσετε ένα εσωτερικό περιβάλλον με μικρόβια που δεν είναι επιβλαβή ή ακόμη και ωφέλιμα».
πηγή φωτογραφίας
Δείτε επίσης Αυτό Είναι Το Γυναικείο Αντικείμενο Που Είναι Πιο Βρώμικο Ακόμα Και Από Τη Λεκάνη Της Τουαλέτας